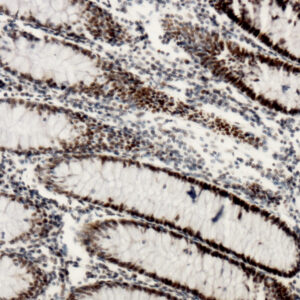
Anti-MLH1

M
Showing 21–40 of 51 resultsSorted by latest
-

Anti-MUC6 (SPM598)
Price range: $269.00 through $945.00 Select options This product has multiple variants. The options may be chosen on the product page -

Anti-MDM2, Clone D-7
Price range: $269.00 through $1,359.00 Select options This product has multiple variants. The options may be chosen on the product page -

Anti-Microglia/AIF1, Clone AIF1/2468
Price range: $269.00 through $1,265.00 Select options This product has multiple variants. The options may be chosen on the product page -

Anti-Melanoma Marker, Clone A103+T311+HMB45
Price range: $269.00 through $1,430.00 Select options This product has multiple variants. The options may be chosen on the product page -

Anti-MSH2, Clone D-9
Price range: $269.00 through $1,485.00 Select options This product has multiple variants. The options may be chosen on the product page -

Anti- MYOD1, Clone rMYD712
Price range: $269.00 through $1,265.00 Select options This product has multiple variants. The options may be chosen on the product page -

Anti-Mesothelin (Mesothelial Marker) [MSLN/2131]
Price range: $269.00 through $1,485.00 Select options This product has multiple variants. The options may be chosen on the product page -

Anti-MSH6 44
Price range: $269.00 through $1,485.00 Select options This product has multiple variants. The options may be chosen on the product page -

Anti-Myogenin (Myf4), Clone MGN185
Price range: $269.00 through $1,399.00 Select options This product has multiple variants. The options may be chosen on the product page -
Anti-MLH1
Price range: $325.00 through $1,485.00 Select options This product has multiple variants. The options may be chosen on the product page -

Anti-MiTF
Price range: $250.00 through $935.00 Select options This product has multiple variants. The options may be chosen on the product page -

Anti-MUC5AC
Price range: $250.00 through $935.00 Select options This product has multiple variants. The options may be chosen on the product page -

Anti-MUC4
Price range: $250.00 through $1,205.00 Select options This product has multiple variants. The options may be chosen on the product page -

Anti-MSH6
Price range: $201.00 through $799.00 Select options This product has multiple variants. The options may be chosen on the product page -

Anti-Mesothelin
Price range: $250.00 through $1,495.00 Select options This product has multiple variants. The options may be chosen on the product page -

Anti-Myf4
Price range: $198.00 through $632.00 Select options This product has multiple variants. The options may be chosen on the product page -

Anti-Mast Cell Tryptase
Price range: $325.00 through $935.00 Select options This product has multiple variants. The options may be chosen on the product page -

Anti-Multi-Drug Resistance Marker (P-Glycoprotein)
Price range: $250.00 through $935.00 Select options This product has multiple variants. The options may be chosen on the product page -

Anti-Muscle Actins
Price range: $228.00 through $615.00 Select options This product has multiple variants. The options may be chosen on the product page -

Anti-Myelin Basic Protein
Price range: $269.00 through $1,239.00 Select options This product has multiple variants. The options may be chosen on the product page

